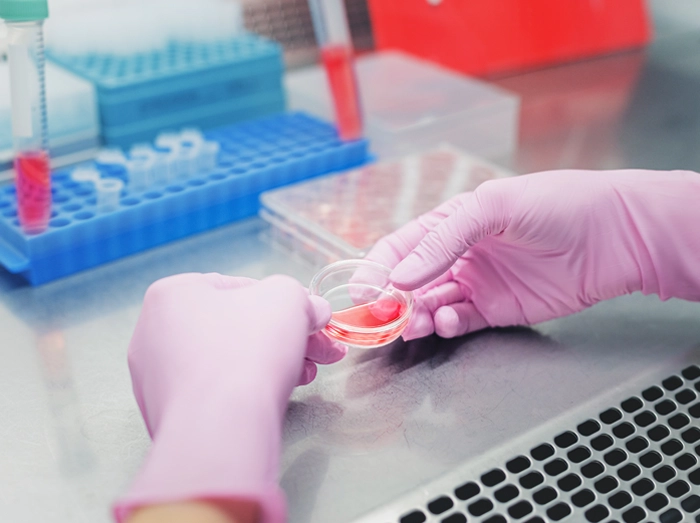

ΑΝΟΣΟΛΟΓΙΚΕΣ ΕΞΕΤΑΣΕΙΣ
Έλεγχος του ανοσοποιητικού συστήματος,
του μηχανισμού άμυνας του οργανισμού μας!
Κλείστε ραντεβού στο Διαγνωστικό Κέντρο ΠΑΤΡΙΑΡΧΕΑΣ, στην Πάτρα
Οι ανοσολογικές εξετάσεις είναι εργαστηριακές δοκιμές που χρησιμοποιούνται για να αξιολογηθούν διάφορες πτυχές του ανοσοποιητικού συστήματος του σώματος. Αυτές οι εξετάσεις βοηθούν στη διάγνωση και παρακολούθηση λοιμώξεων, αυτοάνοσων νοσημάτων, αλλεργιών και άλλων ανοσολογικών διαταραχών.

Κατηγορίες Ανοσολογικών Εξετάσεων
1. Εξετάσεις Αντισωμάτων
Αντισώματα IgM, IgG, IgA: Μετρούν τα επίπεδα των ανοσοσφαιρινών στο αίμα και βοηθούν στη διάγνωση λοιμώξεων και ανοσολογικών ανεπαρκειών.
Αντισώματα κατά συγκεκριμένων μικροοργανισμών (π.χ. αντισώματα κατά του ιού της ηπατίτιδας, του HIV, του EBV): Αξιολογούν την παρουσία και την έκταση λοιμώξεων από συγκεκριμένα παθογόνα.
Αντιπυρηνικά Αντισώματα (ΑΝΑ): Χρησιμοποιούνται για τη διάγνωση αυτοάνοσων νοσημάτων, όπως ο λύκος.
Αντισώματα κατά του Θυρεοειδούς (Anti-ΤΡΟ, Anti-Tg): Ενδεικτικά αυτοάνοσων νοσημάτων του θυρεοειδούς, όπως η θυρεοειδίτιδα Hashimoto.
2. Εξετάσεις Κυττάρων του Ανοσοποιητικού
Λεμφοκυτταρομέτρηση: Μετρά τον αριθμό και τις υποκατηγορίες των λεμφοκυττάρων (π.χ. Τ-κύτταρα, Β-κύτταρα, φυσικά κύτταρα φονείς).
CD4/CD8: Αξιολογεί την αναλογία των Τ-βοηθητικών κυττάρων (CD4) προς τα κυτταροτοξικά Τ-κύτταρα (CD8). Χρήσιμη στη διαχείριση του HIV/AIDS και άλλων ανοσολογικών διαταραχών.
3. Δείκτες Φλεγμονής και Ανοσολογικής Απόκρισης
C-Αντιδρώσα Πρωτεΐνη (CRP): Ενδεικτική οξείας φλεγμονής στο σώμα.
Ρευματοειδής Παράγοντας (RF): Χρησιμοποιείται στη διάγνωση της ρευματοειδούς αρθρίτιδας.
Ταχύτητα Καθίζησης Ερυθρών (ESR): Έμμεσος δείκτης φλεγμονής και χρόνιων φλεγμονωδών καταστάσεων.
Προκλινική Ανοσολογία (π.χ., IFN-gamma, IL-2): Μετρούν κυτοκίνες και άλλους δείκτες της ανοσολογικής απόκρισης.
4. Εξετάσεις Αλλεργιών
Δοκιμασίες Αλλεργίας (RAST, ELISA): Μετρούν τα επίπεδα συγκεκριμένων αντισωμάτων IgE που σχετίζονται με αλλεργικές αντιδράσεις σε διάφορα αλλεργιογόνα.
Δερματικές Δοκιμασίες: Διεξάγονται για την άμεση αντίδραση του δέρματος σε συγκεκριμένα αλλεργιογόνα.
5. Συμπληρωματικό Σύστημα
- Συμπληρώματα C3 και C4: Αξιολογούν τη λειτουργία του συμπληρωματικού συστήματος, μέρος της ανοσολογικής απόκρισης.
- CH50 (Συνολική Αιμολυτική Δραστηριότητα του Συμπληρώματος): Μετρά τη συνολική δραστηριότητα του συμπληρωματικού συστήματος.

Σημασία των Ανοσολογικών Εξετάσεων
Διάγνωση Λοιμώξεων: Βοηθούν στην ανίχνευση οξείας και χρόνιας μόλυνσης από βακτήρια, ιούς και άλλους μικροοργανισμούς.
Διάγνωση Αυτοάνοσων Νοσημάτων: Ανιχνεύουν την παρουσία αυτοαντισωμάτων και άλλων δεικτών που σχετίζονται με αυτοάνοσες διαταραχές.
Παρακολούθηση Ανοσοθεραπειών: Ελέγχουν την αποτελεσματικότητα θεραπειών που επηρεάζουν το ανοσοποιητικό σύστημα.
Ανίχνευση Αλλεργιών: Βοηθούν στη διάγνωση και διαχείριση αλλεργικών αντιδράσεων.
Αξιολόγηση Ανοσολογικής Λειτουργίας: Ελέγχουν την γενική κατάσταση και λειτουργικότητα του ανοσοποιητικού συστήματος.
Οι ανοσολογικές εξετάσεις είναι ζωτικής σημασίας για την πλήρη κατανόηση και διαχείριση της υγείας σας, επιτρέποντας στους γιατρούς να λάβουν στοχευμένες και αποτελεσματικές αποφάσεις για τη θεραπεία και την πρόληψη νοσημάτων.
Προτεραιότητά μας, στο Διαγνωστικό Κέντρο ΠΑΤΡΙΑΡΧΕΑΣ, στην Πάτρα, είναι η παροχή υπηρεσιών υγείας υψηλού επιπέδου!
Κλείστε ραντεβού για ανοσολογικές εξετάσεις
